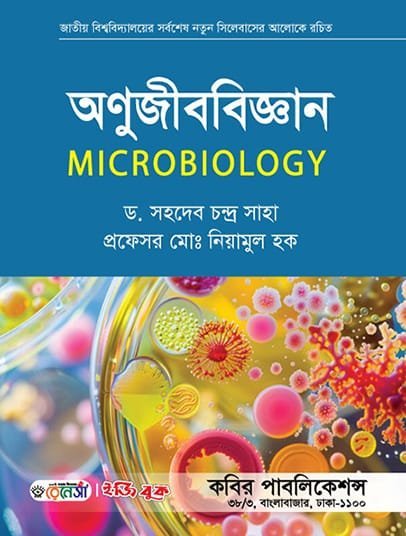

অনার্স প্রথম বর্ষ-আবশ্যিক ইতিহাস ও আইসিটি ইজি বুক (Hons 1st year-Compulsory History and ICT Easy Book)
300.00৳ Original price was: 300.00৳ .240.00৳ Current price is: 240.00৳ .
জাতীয় বিশ্ববিদ্যালয়ের অনার্স প্রথম বর্ষ বিভাগের শিক্ষার্থীদের জন্য এই বইটি অত্যন্ত যত্নসহকারে রচনা করা হয়েছে। জটিল বিষয়গুলো সহজ ও সাবলীলভাবে উপস্থাপন করা হয়েছে যাতে শিক্ষার্থীরা পরীক্ষায় ভালো ফলাফল করতে পারে।
বইটির মূল বৈশিষ্ট্যসমূহ:
-
✅ সিলেবাস ভিত্তিক: জাতীয় বিশ্ববিদ্যালয়ের সর্বশেষ কারিকুলাম ও সিলেবাস অনুযায়ী রচিত।
-
✅ সহজ উপস্থাপনা: প্রতিটি অধ্যায় এমনভাবে সাজানো হয়েছে যা মনে রাখা সহজ।
-
✅ কমন প্রশ্ন: বিগত বছরের প্রশ্ন এবং ১০০% কমন উপযোগী সাজেশন্স অন্তর্ভুক্ত।
-
✅ নির্ভুল তথ্য: অভিজ্ঞ শিক্ষকমণ্ডলী দ্বারা সম্পাদিত ও সংশোধিত।
| Part |
1 ,2 ,All |
|---|
MAECENAS IACULIS
Vestibulum curae torquent diam diam commodo parturient penatibus nunc dui adipiscing convallis bulum parturient suspendisse parturient a.Parturient in parturient scelerisque nibh lectus quam a natoque adipiscing a vestibulum hendrerit et pharetra fames nunc natoque dui.
ADIPISCING CONVALLIS BULUM
- Vestibulum penatibus nunc dui adipiscing convallis bulum parturient suspendisse.
- Abitur parturient praesent lectus quam a natoque adipiscing a vestibulum hendre.
- Diam parturient dictumst parturient scelerisque nibh lectus.
Scelerisque adipiscing bibendum sem vestibulum et in a a a purus lectus faucibus lobortis tincidunt purus lectus nisl class eros.Condimentum a et ullamcorper dictumst mus et tristique elementum nam inceptos hac parturient scelerisque vestibulum amet elit ut volutpat.

Reviews
Clear filtersThere are no reviews yet.